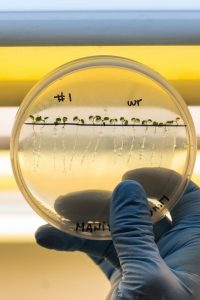

Instituto de Investigaciones en Biodiversidad y Biotecnología (INBIOTEC-CONICET)
El INBIOTEC fue creado en el año 2012, siendo su principal objetivo desarrollar y generar actividad intelectual creativa, llevando adelante proyectos de investigación y desarrollo que atienden a problemáticas vinculadas con el sector agropecuario, medioambiental y bioenergético, con énfasis en el estudio de la biodiversidad nativa.
El INBIOTEC fue creado en el año 2012, siendo su principal objetivo desarrollar y generar actividad intelectual creativa, llevando adelante proyectos de investigación y desarrollo que atienden a problemáticas vinculadas con el sector agropecuario, medioambiental y bioenergético, con énfasis en el estudio de la biodiversidad nativa.
Este instituto está integrado por grupos de investigación con una larga trayectoria en el Centro de Investigaciones Biológicas de la Fundación para Investigaciones Biológicas Aplicadas (FIBA) y en el BIOLAB-Azul (Laboratorio de Biología Funcional y Biotecnología de la Fac. de Agronomía, UNCPBA). En la actualidad, el INBIOTEC cuenta con tres grupos vinculados: el BIOLAB-Azul, el GENEBSO (Grupo de Entomología Edáfica Bonaerense Sudoriental) del Depto. de Biología de la FCEyN-UNMdP, y el QUIAMM (Grupo de Investigación en Química Analítica y Modelado Molecular) del Depto. de Química de la FCEyN-UNMdP.
Los proyectos que se llevan a cabo se agrupan en cinco áreas temáticas: Microbiología Agrícola, Biotecnología Ambiental, Biotecnología y Biología Funcional de Plantas, Biotecnología y Fisiología Molecular de Microalgas y Entomología Aplicada.
Autoridades: Director: Dr. Leonardo Curatti | Vicedirectora: Dra. Corina Berón
Contacto: Vieytes 3103 | Mar del Plata | info@inbiotec-conicet.gob.ar | www.inbiotec-conicet.gob.ar